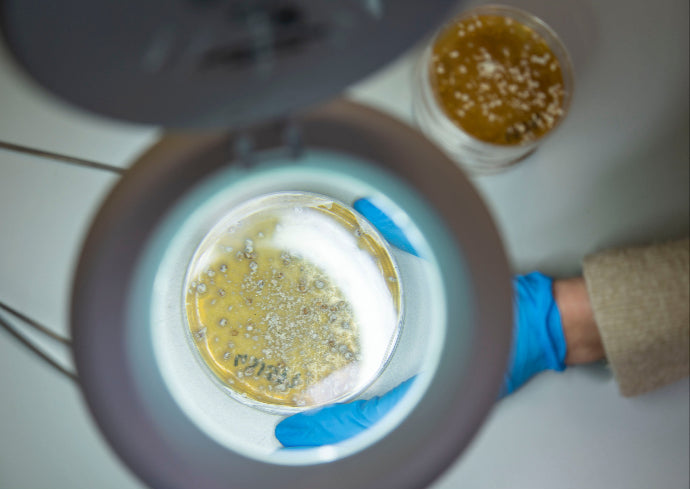

Technology & Innovation
RAPID GROWTH & INFINITELY RENEWABLE RESOURCE |
PRECISION MANUFACTURING ENSURES ACCURACY AND EFFICIENCY |

Unlocking the Power of Mycelium
Mycelium, the root structure of mushrooms, is an infinitely renewable resource that rapidly grows in just a few days.
Our AirMycelium® platform directs fibers to grow into the air while self-assembling in highly controlled environments of vertical farms. With precision manufacturing and environmental control, we create sustainable materials with unmatched accuracy and efficiency.


Our farm operations boast a capacity of 1.5 million square feet, with the ability to tap into a global supply chain of vertical mushroom farms that can deliver up to 450 million square meters annually.
We leverage existing tanning infrastructure for our raw hides, ensuring extensive finishing options for our customers.
Mycelium Quick Facts
Rapid Growth in Days
Proprietary AirMycelium® Platform
Hyper Renewable Resource
Naturally Grown Structure
Finished by Tanneries

The Forager Foundry: Your Partner in Transforming Tomorrow
Driven by molecular manufacturing and advanced bioreactors, Forager’s proprietary technology ensures technical excellence and rapid scalability.
With over 15 years of experience, 165+ patents, custom strain and substrate research, and proprietary tools, we are partnering with premier global brands on new textile and foam solutions.